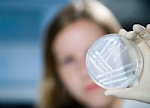

Новости и статьи
Масс-спектрометрия в органической химии Выдержка из книги А. В. Лебедева К концу XX века инструментальные физико-химические методы анализа стали неотъемлемой частью экспериментальной работы исследователя, работающего в области естественных наук. Наиболее мощными и многоцелевыми среди них, безусловно, являются спектроскопия ядерного магнитного резонанса и масс-спектрометрия. Оба метода активно используются в химии, биологии, медицине, экологии, контроле технологических процессов, криминалистике и т. д. Характеризуя вновь синтезированное вещество, исследователь обязан получить и описать его ЯМР и масс-спектры. ...
подробнее
Characterization of Microorganisms by MALDI Mass Spectrometry Catherine E. Petersen, Nancy B. Valentine, and Karen L. Wahl Summary
Matrix-assisted laser desorption/ionization-time-of-flight mass spectrometry (MALDI-TOF MS) for characterization and analysis of microorganisms, specifically bacteria, is described here as a rapid screening tool. The objective of this technique is not comprehensive protein analysis of a microorganism but rather a rapid screening of the organism and the accessible protein pattern for characterization and distinction. This method is based on the ionization of the readily accessible and easily ionizable portion of the protein profile of an organism that is often ...
подробнее
Матричная лазерная десорбционная ионизация, МАЛДИ (Matrix-Assisted Laser Desorption/Ionization, MALDI) 
Настоящий прорыв к анализу сложнейших биоорганических молекул произошел с появлением матричной лазерной десорбционной ионизации. Впервые метод описан во второй половине 80-х годов XX века [177-179]. В 1988 г. были опубликованы результаты анализа белков с массами до 70 ООО Да [180], а в 1990 г. —уже до 116000 Да [181]. Рекордные для масс-спектрометрии массы од¬нозарядных ионов в несколько миллионов дальтон [182] были зарегистрированы именно с помощью матричной лазерной десорбционной ионизации. Одному из первооткрывателей метода Кончи Танаке в 2002 г. присуждена Нобелевская ...
подробнее
Cущность метода, конструкция и принцип работы масс-спектрометров с индуктивно связанной плазмой 
Объекты анализа в масс-спектрометрии с индуктивно связанной плазмой В большинстве случаев объектом анализа в ИСП-МС являются водные растворы. Твердые пробы растворяют с применением кислот и затем анализируют. Наиболее подходящей средой для анализа является разбавленная азотная кислота (2–5%). Общее содержание твердых растворенных веществ в пробе не должно превышать 0,2–0,3% (2–3 г/л) в зависимости от основы. Анализ более концентрированных растворов связан с сильным матричным влиянием, приводящим к подавлению сигнала аналита и нестабильности калибровки из-за быстрого ...
подробнее
Масс-спектрометрия MALDI-TOF/TOF и пробоподготовка AnchorChip для идентификации белков со степенями успеха 95% 
Для того, чтобы понять устройство протеома, требуется идентифицировать тысячи белков из 2D гелевых пятен с высокой скоростью. В принятых в настоящее время высокопроизводительных схемах анализа, в основу которых заложено применение метода масс-спектрометрии MALDI-TOF, обычно менее чем 60 % полученных масс-спектров обеспечивают идентификацию белков. Предложенная здесь схема – пробоподготовка AnchorChip™ с последующим анализом методами MALDI-TOF и TOF/TOF MS с использованием масс-спектрометра ultraflex TOF/TOF – обеспечивает чрезвычайно высокие степени успеха – более 95%. В ...
подробнее
страницы | 1 | 2 | 3 | 4 | 5 |